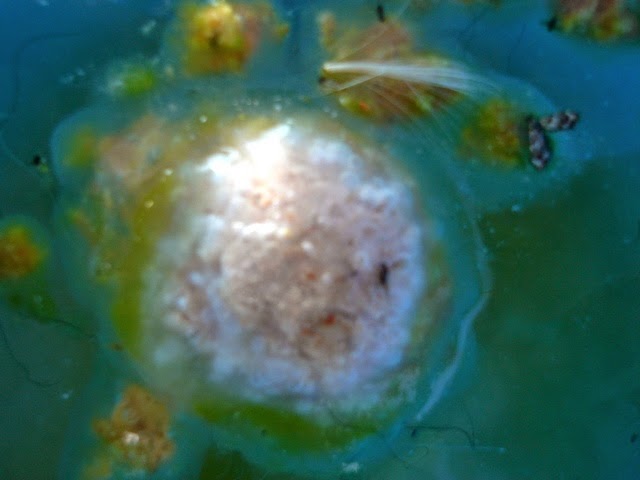

01. Track 01 ...............................................(02:54)
02. Track 02 ...............................................(01:43)
03. Track 03 ...............................................(00:43)
04. Track 04 ...............................................(00:51)
05. Track 05 ...............................................(03:26)
06. Track 06 ...............................................(02:02)
07. Track 07 ...............................................(01:55)
08. Track 08 ...............................................(02:57)
09. Track 09 ...............................................(00:38)
10. Track 10 ...............................................(00:39)
11. Track 11 ...............................................(01:37)
12. Track 12 ...............................................(00:27)
13. Track 13 ...............................................(03:32)
14. Rec.Halls.Hill.Haus. 31 December 2005 ..................(01:22)
15. Rec.Halls.Hill.Haus. 31 December 2005 ..................(02:03)
16. Rec.Halls.Hill.Haus. 31 December 2005 ..................(01:18)
17. Rec.Halls.Hill.Haus. 31 December 2005 ..................(00:44)
18. Rec.Halls.Hill.Haus. 31 December 2005 ..................(02:24)
19. Rec.Halls.Hill.Haus. 31 December 2005 ..................(02:26)
20. Rec.Halls.Hill.Haus. 31 December 2005 ..................(03:37)
21. Rec.Halls.Hill.Haus. 31 December 2005 ..................(01:44)
22. Doih 'ggaw .............................................(01:07)
23. Doih 'ggaw .............................................(00:13)
24. Doih 'ggaw .............................................(06:11)
25. Doih 'ggaw .............................................(00:16)
26. Doih 'ggaw .............................................(00:47)
27. Doih 'ggaw .............................................(00:31)
28. Doih 'ggaw .............................................(00:51)
29. Doih 'ggaw .............................................(01:04)
30. Doih 'ggaw .............................................(00:13)
31. Doih 'ggaw .............................................(00:33)
32. Doih 'ggaw .............................................(00:31)
33. Doih 'ggaw .............................................(00:24)
34. Doih 'ggaw .............................................(00:28)
35. Doih 'ggaw .............................................(00:18)
36. Doih 'ggaw .............................................(00:19)
37. Doih 'ggaw .............................................(07:33)
38. Doih 'ggaw .............................................(00:10)
39. Doih 'ggaw .............................................(00:31)
40. Doih 'ggaw .............................................(00:13)
41. Doih 'ggaw .............................................(00:10)
42. Doih 'ggaw .............................................(00:14)
43. Doih 'ggaw .............................................(00:33)
01-43.MP3 (01:02:12)
folder.jpg
LS173.Back.JPG
LS173.Front.JPG
LS173.Label.jpg
43 Tracks in floom, average track length 1:26
January 2006
DOWNLOAD Ls#173
========================================================================
jampr (01)-(99).JPG
WINDOWS (01)-(58).JPG
NEW MEAGY VIP Audial (01)-(24).MP3_(00:20:40)
-
LIME PAINT TAPE SOUND (01)-(30).MP3_(01:19:41)
JUMPER.rtf
LifeSpace.txt
-
clear reel (01)-(09).MPG_(00:08:30)
Cough Ball (1)001-(1)012.JPG
Cough Ball (1)013.MPG_(00:00:16)
GLOWN (1)-(5).JPG
MIV 1-7.MP4_(00:05:45)
+001.jpg)
+002.jpg)
+003.jpg)
+004.jpg)
+005.jpg)
+006.jpg)
+007.jpg)
+008.jpg)
+009.jpg)
+010.jpg)
+011.jpg)
+012.jpg)
.jpg)
.jpg)
.jpg)
.jpg)
.jpg)